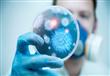
مدير مستشفى الصدر: المصاب الأول بالكورونا يبلغ 28

مدير مستشفى الصدر: المصاب الأول بالكورونا يبلغ 28 سنة وحالته مستقرة
كتبت- شيماء الليثي:
مدير مستشفى الصدر: المصاب الأول بالكورونا يبلغ 28
قال الدكتور محمود عبد المجيد، مدير مستشفى الصدر، إن المصاب الوحيد بفيروس كورونا الشرق الأوسط في مصر حالته الآن مستقرة ومطمئنة.
وأضاف عبد المجيد ، في كلمته خلال مؤتمر عن مخاطر الكورونا بدار الحكمة ، الخميس، أن المريض هو مهندس يبلغ من العمر 28 عاما ، وتم اكتشاف حمله للفيروس بالمطار بعد عودته من زيارة عمه بالمملكة العربية السعودية والذي كان مصابا بالكورونا .
وأشار الطبيب إلى أنه محجوز الآن بأحد غرف العزل الطبي بمستشفى الصدر بالعباسية ، ويستطيع أهله رؤيته عبر زجاج الغرفة ومهاتفته عبر الهاتف المحمول بشكل طبيعي ، مؤكدا أنه لا يخضع لجهاز تنفس صناعي ، إنما يتنفس ويتحرك بشكل طبيعي ولكن داخل نطاق غرفته المعزولة.
وأكد عبد المجيد أن الأطباء بمستشفى الصدر يتعاملون بحذر شديد مع المرضى ، ويستخدمون سبل مكافحة العدوى المتاحة ، خاصة و أن 25 % من المصابين بالمرض حول العالم من العاملين بالفريق الطبي .
في سياقه أوضح عبد المجيد أنه حتى الآن لم يحدث حالة وفاة واحدة بسبب الكورونا ، مؤكدا أن حالة الوفاة التى حدثت بأسوان لم تكن مصابة بالفيروس ولكن كان مجرد اشتباه في الإصابة وما قيل عنه كانت معلومات غير دقيقة ، وهناك فرق كبير بين الاشتباه بالإصابة وثبوت الإصابة بالفعل .
لمتابعة أهم وأحدث الأخبار اشترك الآن في خدمة مصراوي للرسائل القصيرة.. للاشتراك...اضغط هنا